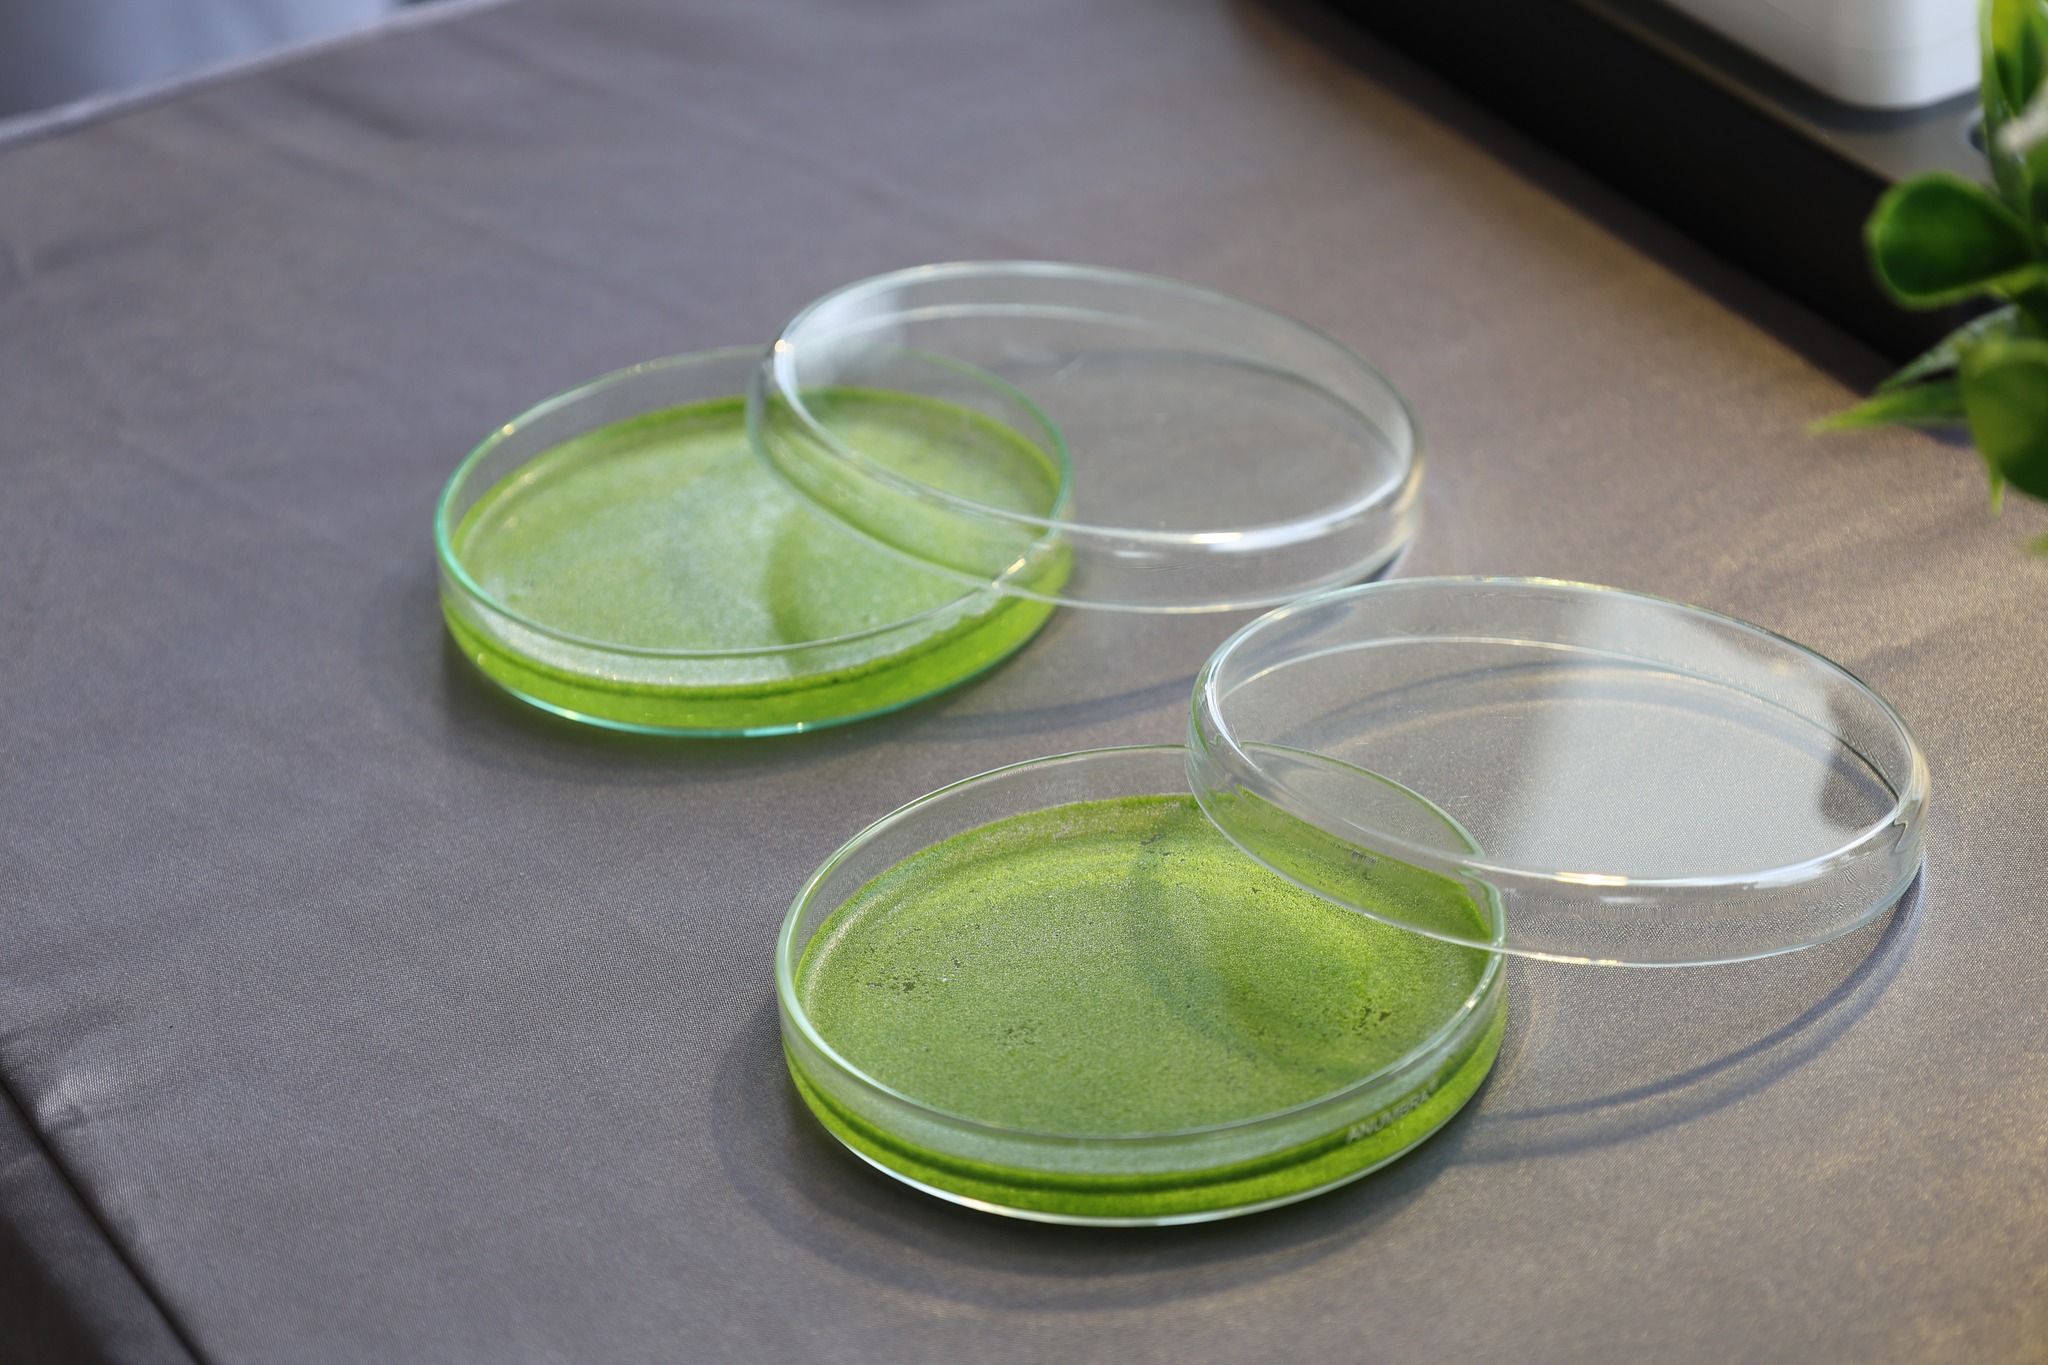

Event Details
Suranaree University of Technology (SUT) partners with Ohkajhu to test and develop research on a liquid nitrate fertilizer generator from air for practical use in Thai agriculture.

Suranaree University of Technology (SUT) partners with Ohkajhu to test and develop research on a liquid nitrate fertilizer generator from air for practical use in Thai agriculture.
Suranaree University of Technology (SUT) and Plook Pak Por Rak Mae Public Company Limited, better known by the brand name "Ohkajhu," have collaborated on an academic project called "Cooperative Research Testing and Development for Utilization." This project will integrate knowledge in electrical engineering, chemistry, and agricultural technology, and translate the research into practical applications for the agricultural industry: a "liquid nitrate (NO₃⁻) fertilizer generator from air using high-frequency electric field technology." This research aims to create production factor stability, reduce production costs, and significantly enhance sustainability in the agricultural sector.
On this occasion, Associate Professor Dr. Anan Thongra-ar, President of SUT, Mr. Chalakorn Ekchaipatanakul, Chief Executive Officer, and Mr. Jirayut Phuwapoonphol, Chief Smart Agriculture Officer of Plook Pak Por Rak Mae Public Company Limited, signed a memorandum of understanding for academic cooperation to promote research development, personnel development, and exchange knowledge and experiences to advance research into practical applications. In attendance were Professor Dr. Nueng Tia-amrung, Vice President for Research and Technology Development, Mr. Chatchan Ekchaipatanakul, Advisor to the Executive Committee, along with company executives, the Deputy Director of the Research and Development Institute, SUT faculty members, and researchers. The ceremony took place on August 21, 2025, at the Information Conference Room, SUT Administration Building.
The research project, “A Nitrate (NO₃⁻) Liquid Fertilizer Production Machine from Air Using High-Frequency Electric Field Technology,” by Associate Professor Dr. Chanchai Thongsopa, Head of the Center of Excellence in Electromagnetic Applications, and Assistant Professor Dr. Arak Theera-ampon, Lecturer in the Plant Production Technology Program, School of Agricultural Technology, Suranaree University of Technology, has successfully created a prototype of a Nitrate (NO₃⁻) liquid fertilizer production machine. This fourth-generation research and development process resulted in a highly efficient fertilizer production machine with a power output of approximately 5,000 watts. Costing only 500,000 baht, the machine can continuously produce liquid fertilizer at a rate of approximately 60-70 liters per hour with a nitrate concentration of 1,000 ppm, the highest amount currently available in the world. This machine can operate 24 hours a day, costs only 0.20 baht per liter, and has a payback period of two years. It can also be scaled up to larger sizes and production capacity to support small-scale farmers, community enterprises, and the larger agricultural industry. From field experiments with green oak lettuce and truffles in greenhouse conditions, the results were satisfactory.
To address the widespread use of urea fertilizer, which is highly nitrogenous and suitable for a wide variety of crops, its high price and reliance on imports necessitates significant production costs for farmers. Furthermore, the traditional urea production process involves multiple steps and is extremely energy-intensive, tied to global energy prices and its environmental impact through greenhouse gas emissions. Therefore, researchers have initiated the development of a "nitrate-from-air liquid fertilizer generator" that eliminates the need for prior urea production, resulting in virtually no production costs and significant environmental protection. It also has the potential to reduce reliance on imports and enable domestic fertilizer production at low cost. The machine utilizes high-frequency electric fields to release sufficient energy to alter the molecular structure of water (H₂O). It also draws nitrogen (N₂) and oxygen (O₂) from the air, which comprise 78% and 21% of natural nitrogen, respectively, into a new chemical bond formation process, producing nitrate (NO₃⁻) and nitrite (NO₂⁻), forms of nitrogen readily absorbed and utilized by plants.
Suranaree University of Technology (SUT) and Plook Pak Por Rak Mae Public Company Limited (Public Company) in Chiang Mai Province will collaborate on an academic project called "Cooperation in Testing and Developing Research for Utilization." Suranaree University of Technology will provide personnel with expertise and academic knowledge, while Plook Pak Por Rak Mae Public Company Limited will provide space for research and development testing. The cooperation will last for three years.